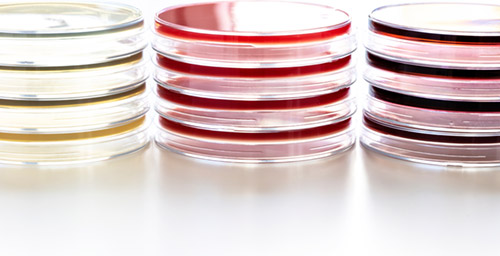
Lipoid-Kosmetik_Our-Company_Quality-Management_Quality-Control_Text2 Petri dishes to test microbiogy and hygiene

Qualitätskontrolle
Wir legen grössten Wert auf die Qualität unserer Produkte und Rohmaterialien. Die Qualitätskontrolle garantiert die Einhaltung der Spezifikationen und die höchste Produktqualität hinsichtlich organoleptischer, chemischer und mikrobiologischer Parameter. Alle unsere Produkte erhalten chargenspezifische Zertifikate, die sowohl die physikalischen und chemischen Eigenschaften als auch den mikrobiologischen Status enthalten.
Chemische und physikalische Analyse
Unsere Rohstoffe und Verkaufsprodukte durchlaufen strenge Prüfverfahren, um zu gewährleisten, dass nur Produkte von höchster Qualität unser Haus verlassen. Deshalb wird für jede Charge die Einhaltung der vordefinierten Produktspezifikationen mit etablierten Analysemethoden überprüft.
Die folgende Liste zeigt einige der Analysen, die wir in unserem Labor durchführen:
- Stickstoffbestimmung
- Wassergehalt
- UV/VIS
- Polyphenolanalyse
- Farbskala
- HPTLC
- HPLC
- Siebanalyse
- Peroxidzahl
- Jodzahl
- Säurezahl

HPTLC-Fingerabdruck von HerbaGlow® NRG. Unsere Full-Spectrum Mild Extraction Technologie ermöglicht die Extraktion aller lösungsmittellöslichen Moleküle.
Mikrobiologie und Hygiene
Im Rahmen der mikrobiologischen Qualitätskontrolle werden unsere Produkte auf Sicherheit im Sinne der Keimbelastung geprüft. Die Bestimmung von aeroben Bakterien, Hefen und Schimmelpilzen, sowie der Ausschluss spezifischer pathogener Mikroorganismen, erfolgen mittels validierter mikrobiologischer Kulturen und Screeningverfahren. Die mikrobiologischen Methoden und Spezifikationen werden in Anlehnung an die empfohlenen Richtlinien der ISO 21149:2006 Norm und des Europäischen Arzneibuches (Pharm. Eur.) erstellt.
Darüber hinaus bilden Hygienemassnahmen und Prozesswasserkontrollen wesentliche Elemente unseres Produktionszyklus. Auf Basis von Standardarbeitsanweisungen (SOP) überwachen wir diese Parameter sehr genau und reagieren auf etwaige Abweichungen. Die Anwendung einer guten Hygienepraxis und das Hygienebewusstsein werden intern durch regelmässige Schulungen gefördert.
- Qualitätsmanagement
- Qualitätspolitik
- Qualitätskontrolle
- Regulatory Affairs